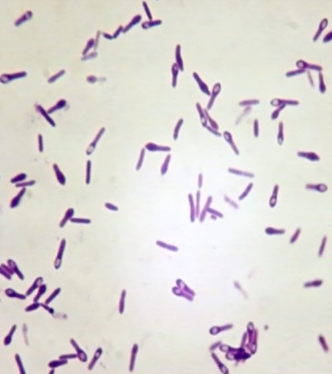

characteristics of clostridium spp
gram positive rods
strict anaerobic organisms
spore forming
-show bulge
-location of spore can help ID
what is the causative agent of tetanus
clostridium tetani
-terminal spherical endospore (tennis racket shape)
what things can cause tetanus
-horses and humans highly susceptible
-carnivores are resistant

what are the the conditions for clostridium tetani to infect susceptible host
-spores introduced into the wound, needs to be anaerobic conditions
-anaerobisis caused by deep wound penetration and necrotic tissue
-facultative anaerobes in polymicrobic infection consume oxygen to allow that spores to germinate creating an environment for obligate anaerobes
what types of potent toxins are the vegetative cells in clostridium tetani producing
-tetanolysin: hemolytic spore forming toxin that lyses RBC
-tetanospasmin (tetanus neuron toxin): most potent toxin
what is the pathogenesis of tetanospasmin in clostridium tetani
AB subunit bind to presynaptic terminal of LMN > gets internalize > released A in motor neruon > gets up to the inhibitory neuron > blocks the release of gamma aminobutyric acid (GABA) and glycogen inhibitory neurotransmitter
-leading to spastic paralysis
diseases of clostridium tetani
rigid paraylsis
-ascending (for not susceptible animals) and descending (for highly susceptible animals)
-lockjaw (no feeding) - truisms
-raise eyebrows ad grinning
-sawhorse (stance)
diagnosis for clostridium tetani
-gram stain
-PCR for tetanus toxin genes from wound
-differentiate from strychnine poisoning dogs
treatment for clostridium tetani
-horses given antitoxin q12 along w muscle relaxants and barbiturates
-dogs and cats can give horse one but can cause anaphylaxis
-surgical debridment of wound
-supportive care bc toxins bind irreversibly so that synapse can regenerate
how to prevent clostridium tetani
-vaccination of farm animals yearly
-mares vax during last 6 weeks of pregnancy
-foals vax 5-8 weeks
why do you need to vaccinate regularly an animal that survived tetanus?
because antibiotic don’t kill endospores, and the endospores can persist and can germinate later on
what is the causative agent of botulism
clostridium botulinum
characteristics of clostridium botulinum
-gram + rods
-obligate anaerobes
-endospore subterminal endospores, bulge like mother cell
where are the endospores of botulism found?
endospores distributed in soils and aquatic environment
what are the 7 types of toxins for botulism?
A, B, C, D, E, F, and G
when choosing an antitoxin for botulism what is the most important for it be an effective treatment?
antitoxin must match toxin
what is the most common toxin in cattle and what part if the cow contains the toxin?
bones and meat contain BoNT
what type pf paralysis is seen with C. botulinum?
flaccid paralysis
what is shaker foal syndrome
in horses from type B toxin (C. botulinum)
-foal found dead or progressive symmetric motor paralysis
how does botulinum neurotoxin cause disease?
eters the cytosol of host cell and cleaves SNARE proteins required for membrane fusion of synaptic vesicle and cell membrane > blocks release of AcH
what are the clinical manifestations of C. botulinum
-tongue, jaw, and tail flaccidity
-incordination and knuckling fetlocks
-flaccid paralysis
how do you diagnose clostridium botulinum?
eliminated other possible causes
-history, clinical signs, and ID of BoNT in serum/tissue before death
why are you likely unable to culture C. botulinum from non-toxicoinfections cases?
C. botulinum does grow well in the gut
-toxin is what is important for the disease not the bacteria
why is the toxin not useful in dead carcasses C. botulinum?
environmental organisms used to deregulate dead carcasses > false positive







